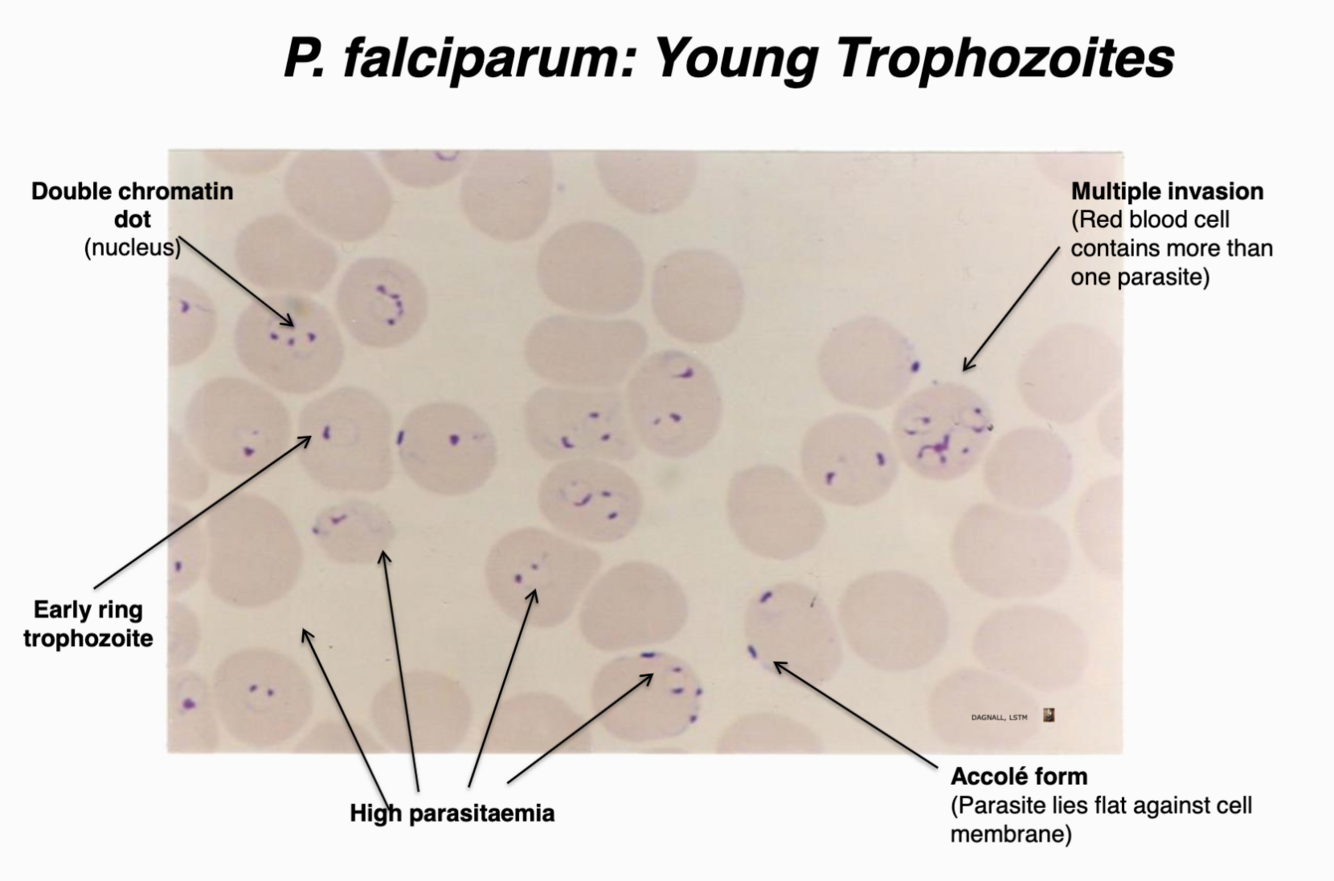
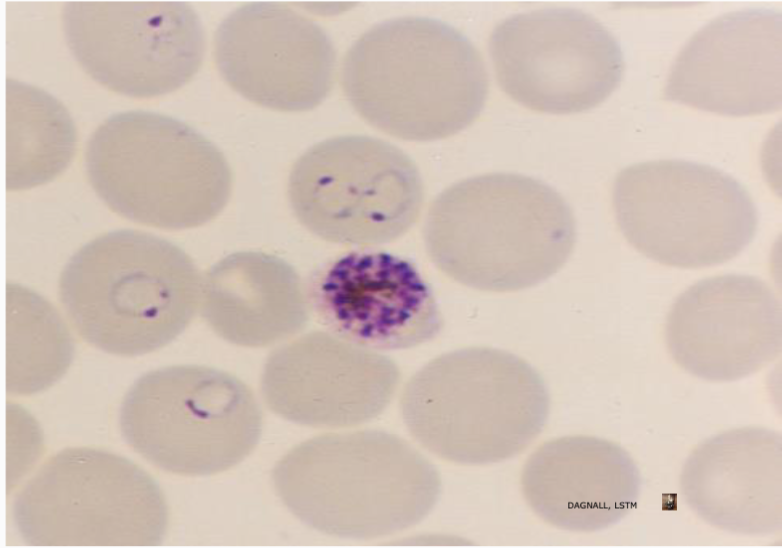
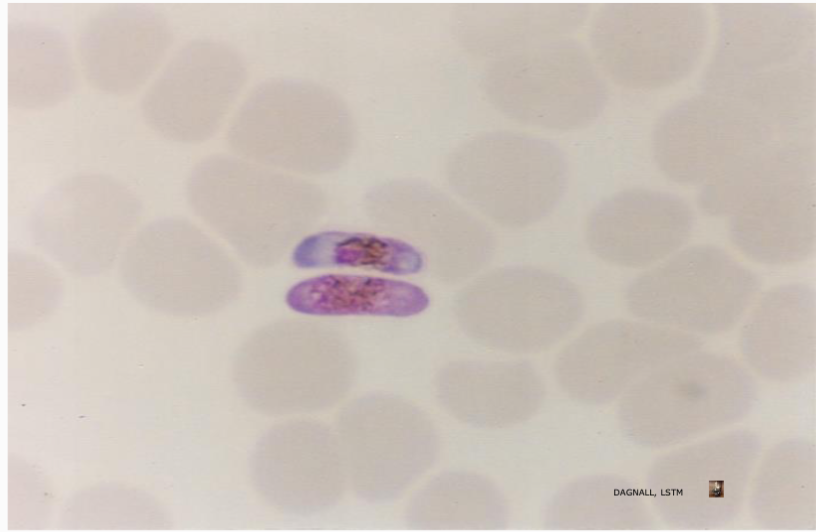
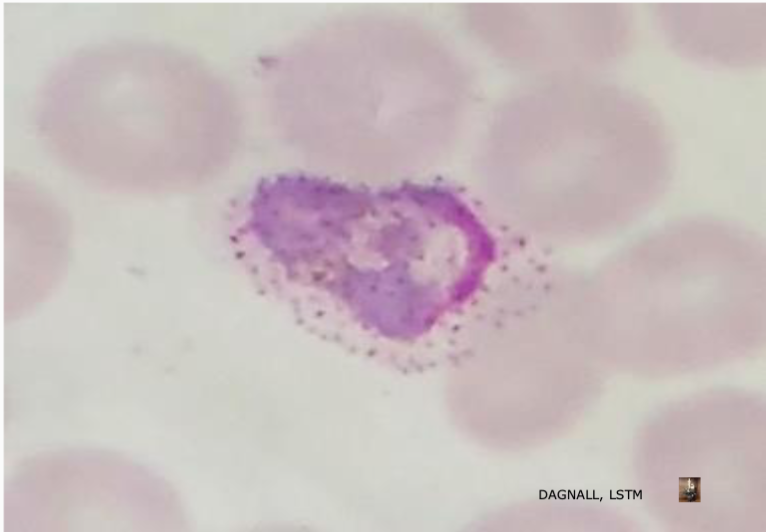
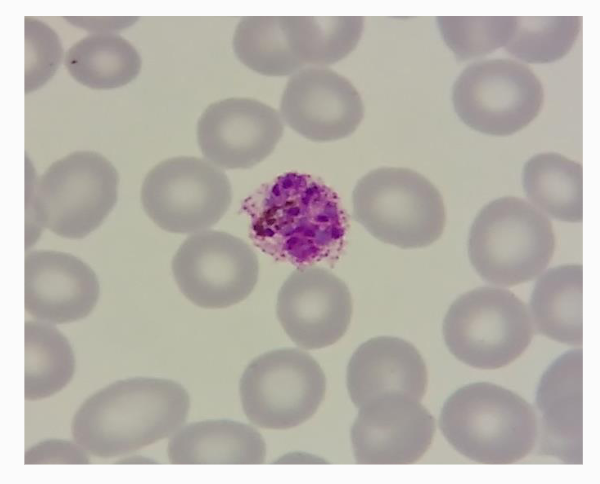
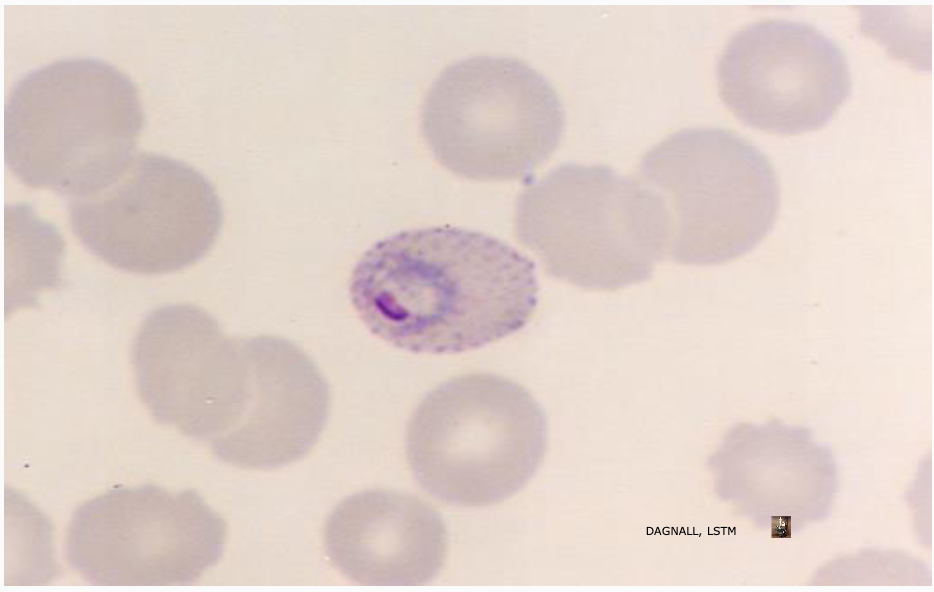
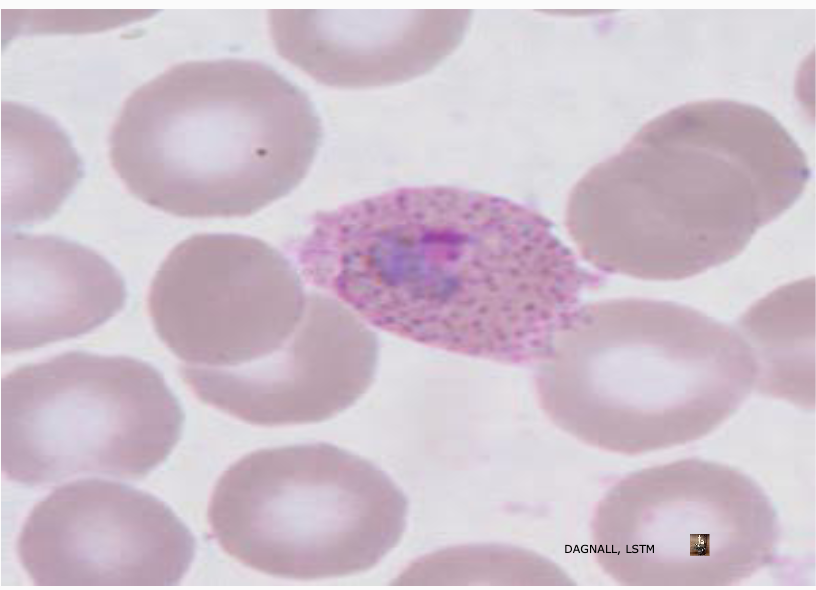
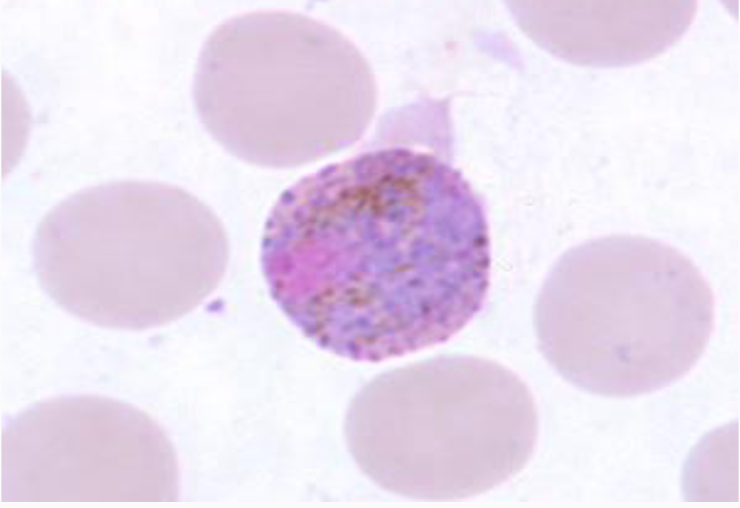
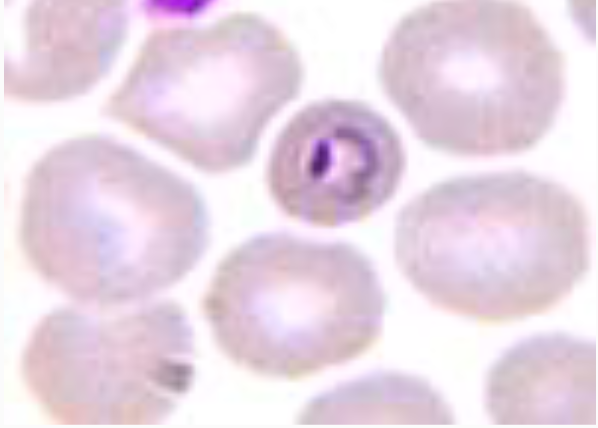
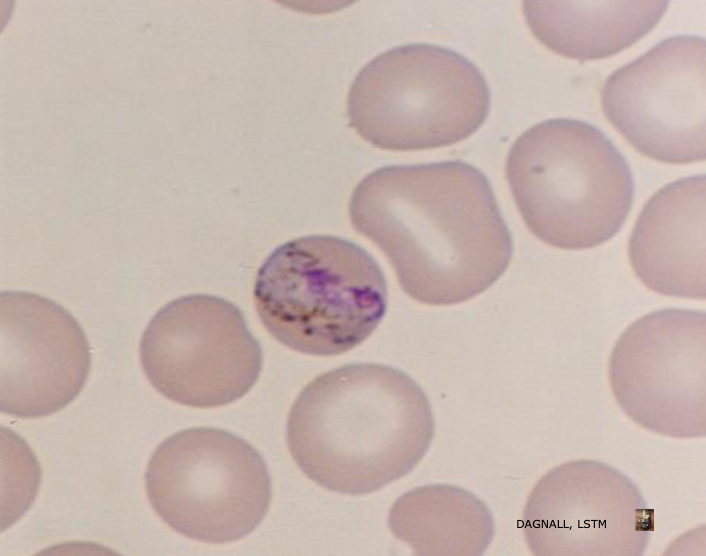
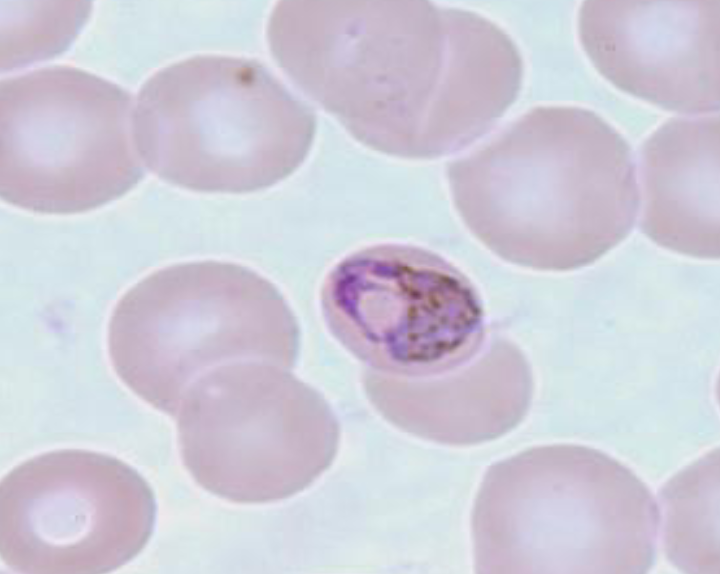
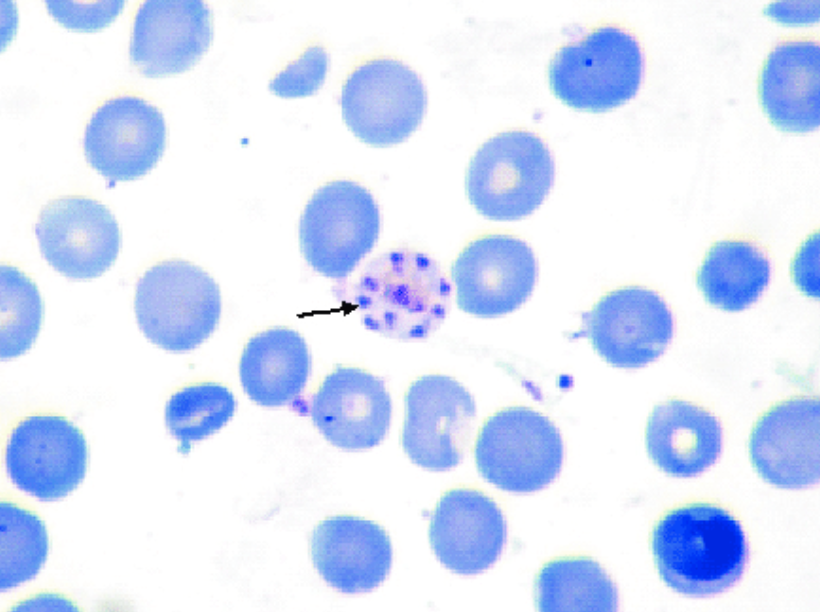
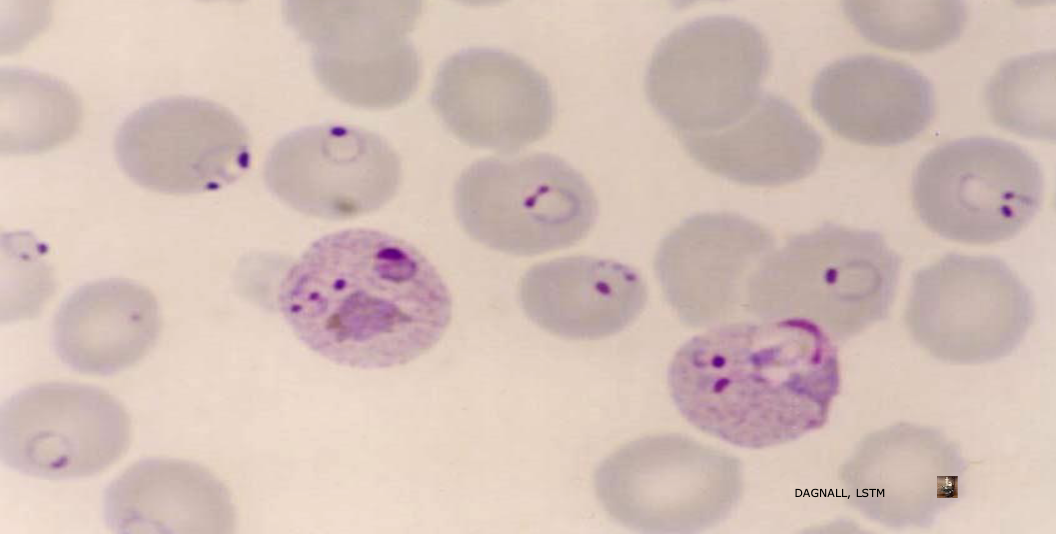
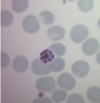

Describe this

Thin film showing late stage ring trophozoites of P.Falciparum in parasitized red cells
- Maurer’s clefts/dots
- knobs on cell wall (crenation)
- thicker parasite cytoplasm
What are some features of young trophozoites of P.Falciparum?
delicate small rings
scanty cytoplasm
accolé form (nucleus at edge of RBC)
multiple invasion
double chromatin dots
What is this?
Schizont of p.falciparum
Rare in P. falciparum except in
heavy infections. Contains 16-36
merozoites.
What is haemazoin?
As malaria parasites feed, they ingest haemoglobin from within the red cell, malaria pigment (haemozoin) is
produced as an end product of haemoglobin breakdown.
This accumulates within the red cell, appearing as brown-black refractive granules within the infected red cell.
It is often seen in late stages, schizonts and gametocytes.
What are these?

What are the defining features of a thin blood film that lead to p.falciparum diagnosis?
- Infected RBC normal shape and size
- Ring stage predominant-may have one or two chromatin dots
- Often 2 or more parasites in 1 red cell
- Crescent shaped gametocytes are diagnostic
- Rare schizonts in blood films (8-24 merozoites)
- Parasitaemia can be very high!
Describe this
P.Vivax older trophozoite
- enlarged, amoeboid parasatised RBC
- irregular mass of blue cytoplasm
- visible Schuffners dots
- large red nucleus to one side
What are the features of p.vivax gametocytes?
Gametocytes are large, solid, and usually rounded, filling most of the infected red cell.
There is a single chromatin mass (nucleus) which is either compact (female gametocytes) or more diffuse
(male gametocytes)
The parasitised red cell is enlarged and Schűffners dots are usually visible. These fine
pigment granules may be scattered throughout the cytoplasm

What is this?
Immature p.vivax schizont with 8
nuclei (haemozoin visible)
What is this?


What is this?

P.Vivax on a thick film.
Enlarged late trophozoites of P.vivax are amoeboid and appear irregular in shape and size when seen in a thick film. The cytoplasm may appear fragmented.
Schűffners dots may also be seen as a pink ‘halo’ surrounding some of the larger parasites.
Large round or oval lysed gametocytes and developing schizonts may be seen in the blood film
What are the diagnostic features of p.vivax on blood film?
RBC is enlarged, Schüffner’s dots are present
All stages may be seen in blood
‘stringy’ parasite cytoplasm
Amoeboid trophozoite is diagnostic
Large round or oval gametocytes
Schizont 16-24 merozoites
What is this?
P.Ovale
Young trophozoite with compact ring form.
The red cell is oval and is only slightly
enlarged.
Clear schűffners dots can be seen
What is this?
P.Ovale
Older trophozoite with a larger nucleus and more solid cytoplasm, Schűffners dots are clearly visible and there is some indication of fimbriation to one side (diagnositic of p.ovale)
What is this?

a P.Ovale schizont
Red cells are usually slightly enlarged and round or oval in shape. Up to 30% will have fimbriated (jagged)
edges.
Parasites are smaller and more compact than P. vivax with Schűffner’s dots visible.
Schizonts have 8-12 merozoites when mature
What is this?
P.Ovale gametocyte
Gametocytes are round and solid looking, filling most of the infected red cell, Schűffner’s dots may be seen
around the periphery.
Malarial pigment is seen in later stages
What does this show?

Thick Film
Plasmodium ovale
Enlarged compact late trophozoites of can be seen.
Schűffners dots may also be seen as a pink ‘halo’ surrounding some of the larger parasites
What is this?
P.Malariae
Young trophozoite
- microcytic parasatized RBC
- deep staining of nucleus and cytoplasm
- no maurers clefts of schuffners dots
What is this?
P.Malariae older trophozoite
- band-form (stretched) nucleus + cytoplasm
- haemazoin visible
- less-defined chromatin dot
What is this?
P. Malariae older trophozoite
- oval parasite is ‘basket-form’
- haemazoin visible
What are features of P.Malariae schizonts?
- In both normal sized or smaller (microcytic) red cells.
- 8-12 merozoites, often arranged in a rosette or irregular cluster
- Mature schizonts nearly fill the host red cell
- Pigment is coarse, golden-brown and usually central
- Schizonts can be common in peripheral blood circulation
In which area of the world are P. falciparum mixed with P. malariae most often seen?
West Africa
In which area of the world are P. falciparum mixed with P. vivax infections most often seen?
South-East Asia
What is an ‘accolé’ form?